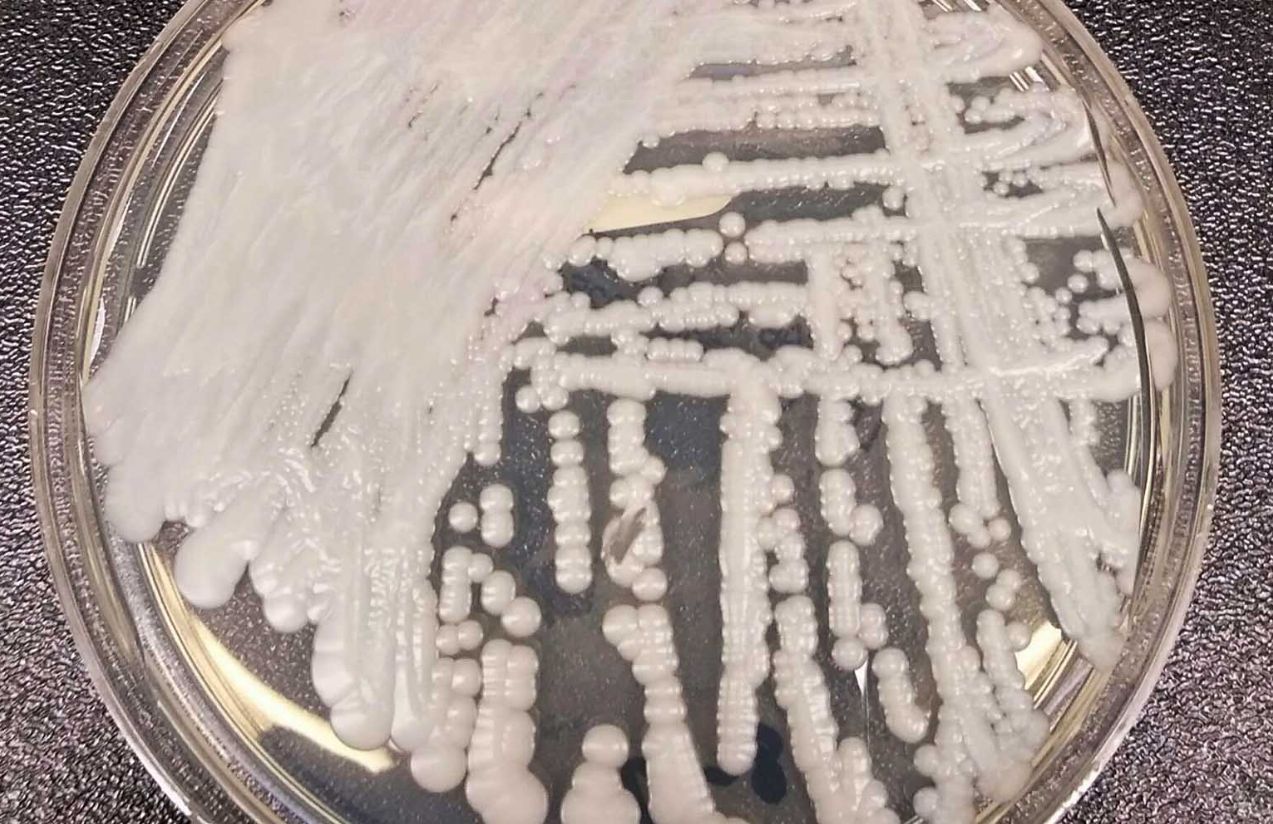
Health alert in the United States: Candida auris fungus spreads in hospitals in New York and New Jersey

Currently, a dangerous drug-resistant fungus is raising concern in hospitals across New York and New Jersey, United States. The organism, known as Candida auris, can cause severe infections and has become difficult to treat because it is resistant to several antifungal medications.
Health experts warn that the fungus can survive for long periods on hospital surfaces, even after cleaning procedures, which makes it easier to spread among patients in healthcare facilities.
Read More
Authorities also note that the overuse of antibiotics can indirectly contribute to the problem, since it disrupts the natural balance of microorganisms in the body and may allow resistant infections to emerge.
Although the risk to the general public is considered low, the fungus poses a serious threat to hospitalized patients, people with severe illnesses, and those with weakened immune systems, who are more vulnerable to life-threatening infections.
What is Candida auris?
It is a fungus that can cause serious infections and is known for being resistant to multiple medications, making it a growing concern in hospitals and healthcare settings.

